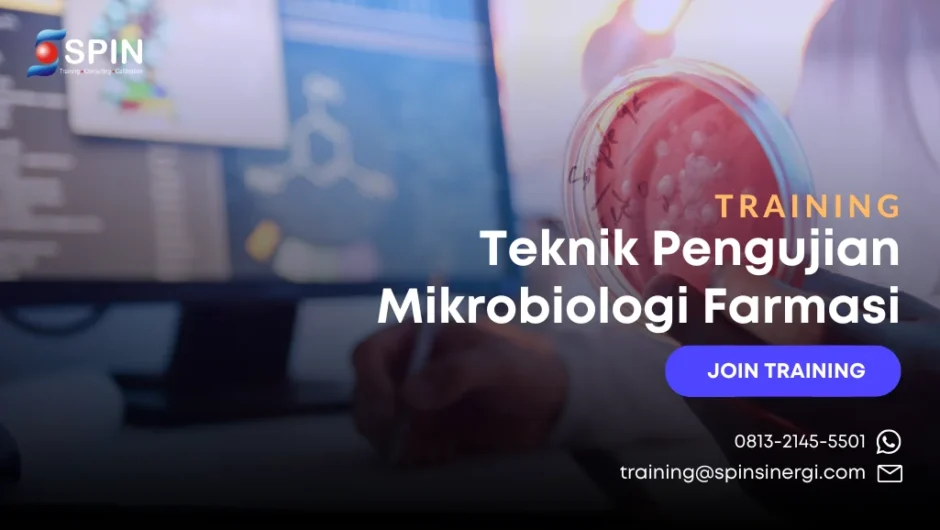
Training Teknik Pengujian Mikrobiologi Farmasi

SPIN Sinergi
Alamat:
Jl. Cikadut No.206,
Karang Pamulang
Kec. Mandalajati
Kota Bandung, Jawa Barat 40194
Telpon : 0227210655
Email: training@spinsinergi.com
No WA: 0813-2145-5501
Jam Buka
- Senin - Jumat 8:00AM - 5:00PM
Sudah lelah menunggu jadwal yang tidak pasti?
Kini Anda bisa langsung ikut public training yang dijamin berlangsung sesuai jadwal!









Berikut ini adalah sebagian pelatihan yang kami selenggarakan.
Setiap pelatihan akan berjalan setelah memenuhi kuota minimal peserta.
Jangan lewatkan kesempatan ini!

SPIN Sinergi
Jl. Cikadut No.206,
Karang Pamulang
Kec. Mandalajati
Kota Bandung, Jawa Barat 40194
Telpon : 0227210655
Email: training@spinsinergi.com
No WA: 0813-2145-5501
Jam Buka